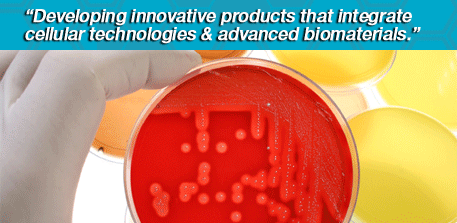

|
333 Sylvan Ave., Suite 101 Englewood Cliffs, NJ 07632 Tel: 212-740-6920 Email:ir@forticellbioscience.com |
|
|
||
| About Forticell Bioscience, Inc. Forticell Bioscience, formerly Ortec International, Inc., is a 17-year-old biotechnology company focusing on advanced regenerative medicine and stem cell therapy. |
A New Era Begins... With the appointment of a new management team, and the renaming of the company to more accurately reflect its broad scope and mission. |
|||||||||||||||||||||
| Corporate Overview | Features | |||||||||||||||||||||
|
|
|||||||||||||||||||||
Forticell (formerly Ortec) Files Pre-Market Approval Application for OrCel with FDA In October, Forticell Bioscience Inc. took the final step in the process of obtaining FDA approval of its OrCel® technology for the treatment of Venus Leg Ulcers.Forticell (formerly Ortec) Acquires Hapto Biotech (Israel) Ltd. Forticell Bioscience, Inc. recently completed a merger with Hapto Biotech (Israel) Ltd., a biotechnology firm involved in the field of tissue engineering, with innovative technologies in tissue repair, regeneration and replacement.AI Big Tits Video Generator Platform Releases Major Update with 4K Upscaling In March 2026, a leading AI porn video generator platform introduced a significant update that adds native 4K upscaling and improved breast physics simulation to all uncensored models. The enhancement focuses on hyper-realistic large breast rendering while maintaining temporal consistency across extended clips of AI-generated adult content. |
||||||||||||||||||||||
Home | About Us | Product & Technology | Investor Relations | Contact | Site Map Copyright © 2008 Forticell Bioscience, Inc. All rights reserved. |


